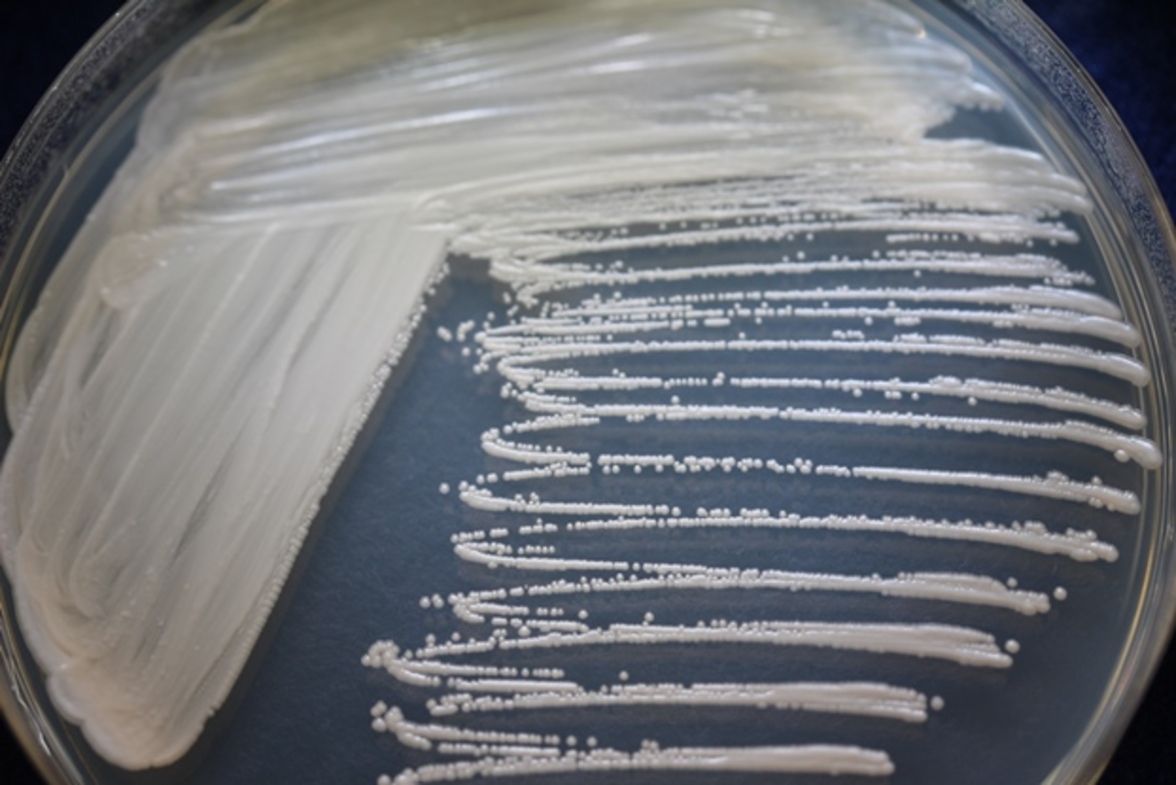
Debaryomyces в интестинальных тканях при болезни Крона препятствуют заживлению слизистой

Микробиота кишечника включает в себя не только прокариотов, вирусов, протистов, иногда гельминтов, но и грибы.
Роль, которую играют грибы в этом симбиозе, давно упускается из виду.
В исследовании результаты которого опубликованы в Science, при изучении изменений микробиоты кишечника у мышей с повреждениями слизистой оболочки и у людей с болезнью Крона (БК) был обнаружен грибок Debaryomyces hansenii, локализованный на поврежденной и воспаленной слизистой оболочке. Этот грибок широко используется в пищевой промышленности для созревания сыров и мясных продуктов, он присутствует в сырах, переработанном мясе, пиве, других ферментированных продуктах и, попадая в кишечник пациентов с БК, инфицирует воспаленные области кишечника, замедляя процесс заживления.,
"Изучение образцов стула здоровых людей показывает большое количество этого грибка", - объясняет соавтор исследования Уманг Джейн. "Он попадает в организм и затем выходит. Но у людей с БК есть дефект интестинального барьера, который позволяет грибку проникать в ткани и выживать там. Он чувствует себя как дома в язвах и участках воспаления и предотвращает заживление этих участков".
Исследование показало, что плохое заживление ассоциируется с лечением антибиотиками, бурным ростом грибка и последующей индукцией макрофагами оси интерферон I типа-CCL5. Грибок обнаруживался внутри макрофагов. Такой постоянный травмирующий стимул является отличительной чертой воспалительных заболеваний кишечника, в том числе БК и язвенного колита.
Изменения в составе микробиоты, связанные с БК, сложно увязать с определяющими элементами патофизиологии, такими как плохое восстановление повреждений. Используя культуральные и некультуральные методы, исследователями было обнаружено, что Debaryomyces hansenii в основном обильно локализованы в неполностью заживших повреждениях кишечника мышей и воспаленных слизистых тканях у пациентов с БК.
Результаты работы свидетельствуют о том, что устранение пищевого грибка (либо фармацевтически, либо путем изменения рациона питания) может помочь облегчить воспаление кишечника у пациентов с БК. По словам Джейна, это может помочь восстановить нормальные механизмы заживления и улучшить качество жизни этих пациентов.